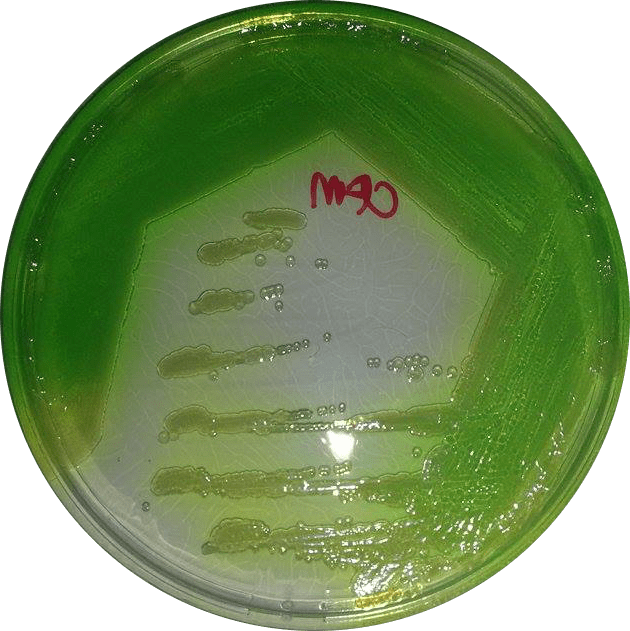

Pseudomonas aeruginosa is problematic pathogen. It is the main cause of mortality of people suffering from Cystic Fibrosis and in hospitals it is associated with wound infections, pneumonia, and a range of other infections. A green colour can often be observed in wounds infected with this organism – the green colour is typical of P. aeruginosa and is a result of the excretion of blue and yellow virulence factors.
This versatile organism has an amazing ability to survive a variety of different environments. It does not need much in the line of nutrients (it is notorious for being able to grow in distilled water) and can even tolerate treatment with some disinfectants and antiseptics. Take triclosan for instance. Triclosan is an antibacterial agent (biocide) that was widely used in variety of antibacterial soaps and cleaning products – that is until the FDA banned the inclusion of triclosan in soaps. For P. aeruginosa this ban was a case of closing the stable door after the horse has bolted though since triclosan resistance is widespread in P. aeruginosa. All the hundreds of P. aeruginosa isolates (isolated from clinical specimens, animals, and wastewater) we have in our collection, are all completely resistant to triclosan. We have also been able to show that certain environments could lead to the selection of P. aeruginosa strains that are co-resistant to both biocides and antibiotics.
Read more about our work on this topic here.
You must be logged in to post a comment.